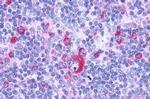
GPR132 Antibody in Immunohistochemistry (Paraffin) (IHC (P))
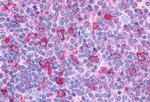
GPR132 Antibody in Immunohistochemistry (Paraffin) (IHC (P))

Search
Invitrogen
GPR132 Polyclonal Antibody
{{$productOrderCtrl.translations['antibody.pdp.commerceCard.promotion.promotions']}}
{{$productOrderCtrl.translations['antibody.pdp.commerceCard.promotion.viewpromo']}}
{{$productOrderCtrl.translations['antibody.pdp.commerceCard.promotion.promocode']}}: {{promo.promoCode}} {{promo.promoTitle}} {{promo.promoDescription}}. {{$productOrderCtrl.translations['antibody.pdp.commerceCard.promotion.learnmore']}}

Please note: We are reviewing Western blot images included in the antibody testing data in our catalog, including those provided by third parties. Unless expressly labeled or annotated as “raw-unedited”, Western blot images included in the antibody testing data in our catalog may have been edited, optimized or otherwise adjusted for presentation.
产品信息
PA1-20393
种属反应
宿主/亚型
分类
类型
抗原
偶联物
形式
浓度
规格
纯化类型
保存液
内含物
保存条件
运输条件
RRID
产品详细信息
Store product as a concentrated solution. Centrifuge briefly prior to opening the vial.
靶标信息
GPCR G2A is a G-protein linked receptor for lysophosphatidylcholine (LPC). It may play a role as a sensor of LPC levels at sites of inflammation to limit tissue-infiltrating-cells and progression to overt autoimmune disease and functions at the G2/M checkpoint to delay mitosis. It also may serve as a mechanism for T and B cells, and other cell types, to slow their proliferation and repair damaged DNA. It is highly expressed in macrophages and hematopoietic tissues rich in lymphocytes, like spleen and thymus, but weakly expressed in heart and lung. In atherosclerotic plaques, expression was observed around the lipid core and at the shoulder region. It is induced by DNA-damaging agents.
仅用于科研。不用于诊断过程。未经明确授权不得转售。
篇参考文献 (0)
生物信息学
蛋白别名: G2 accumulation protein; MGC99642; Probable G-protein coupled receptor 132
基因别名: G2A; GPR132
Entrez Gene ID: (Human) 29933



